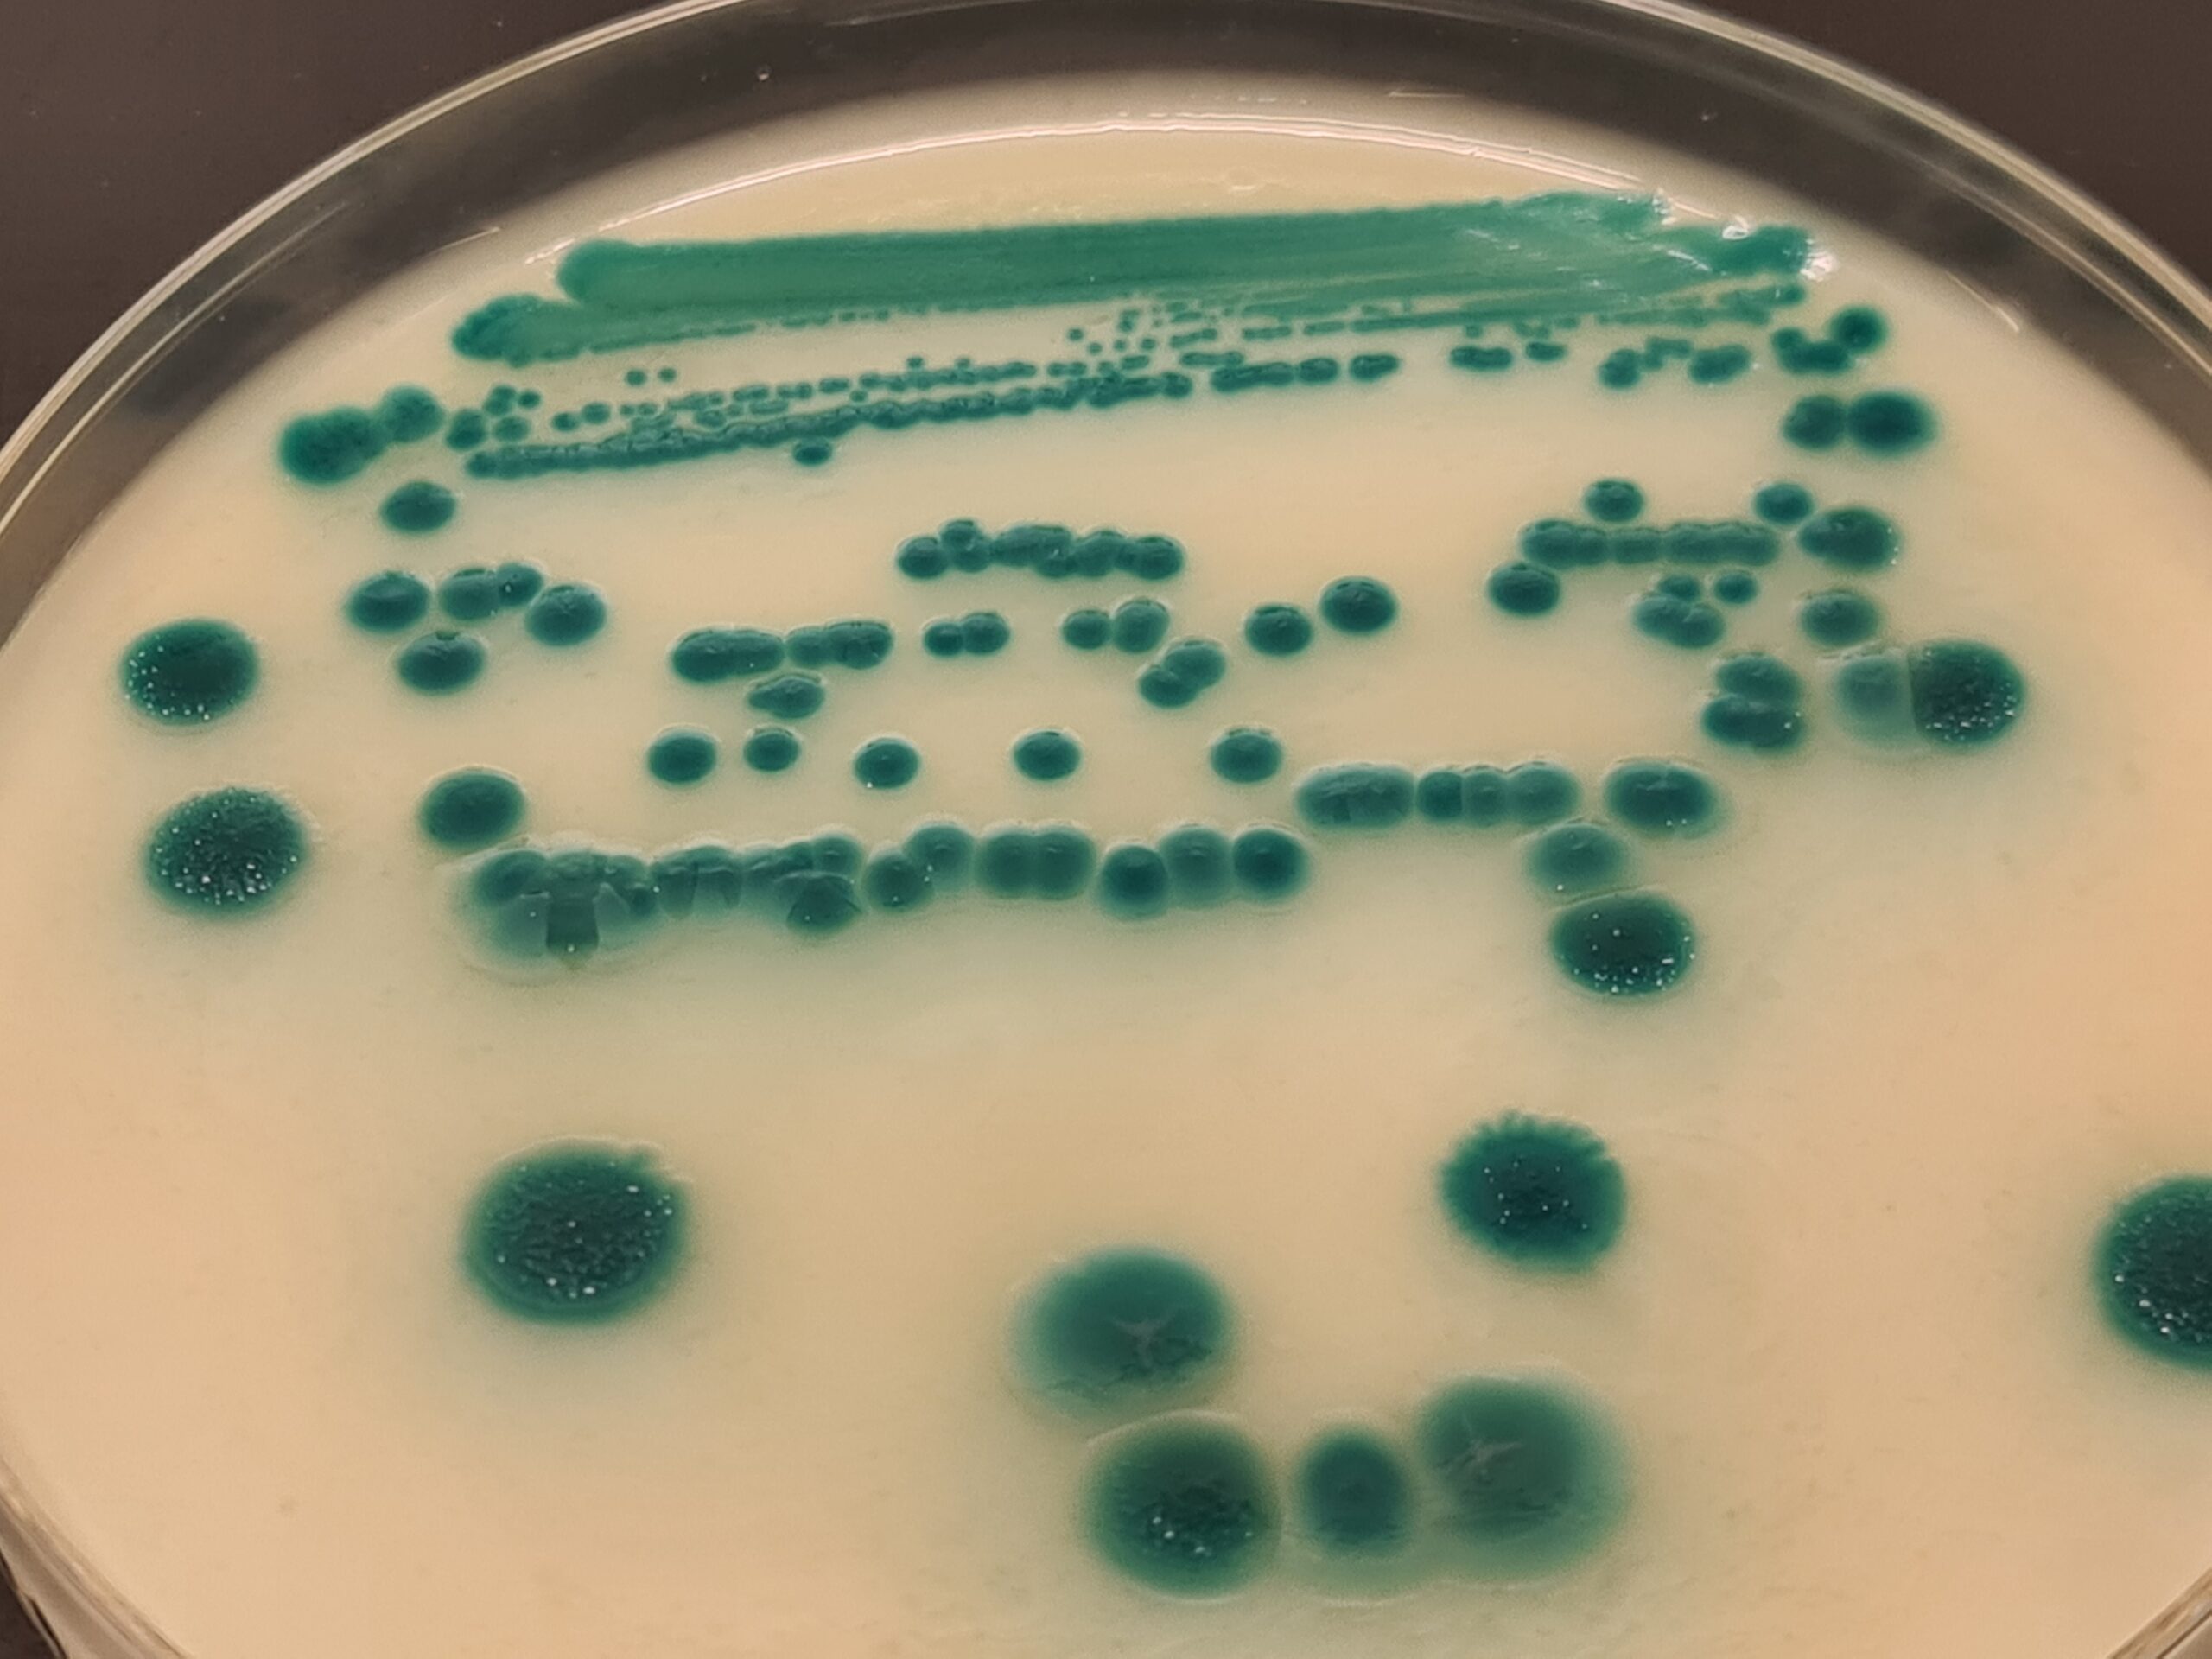

MEDIO DE CULTIVO ISO PARA AISLAMIENTO DIFERENCIAL DE SALMONELLA EN ALIMENTOS, AGUAS Y MEDICAMENTOS
XLD AGAR ISO 6579 PARA AISLAR SALMONELLA
XLD AGAR (XYLOSE LYSINE DESOXYCOLATE)
PHARMACOPEA MEDIO K
Detección de enterobacterias patógenas
(USP, UNE-EN ISO 6579:2003, ISO 6340)
COMPOSICIÓN
Extracto de levadura 3,0 g
Lactosa 7,5 g
Sacarosa 7,5 g
Xilosa 3,5 g
L‑lisina 5,0 g
Cloruro sódico 5,0 g
Desoxicolato sódico 2,5 g
Tiosulfato sódico 6,8 g
Citrato Fe-amoniacal 0,8 g
Rojo fenol 80,0 mg
Agar‑agar 12,5 g
(Fórmula por litro)
pH final: 7,4 ± 0,2
PREPARACIÓN
Disolver 55,1 g de medio en 1 litro de agua destilada. Calentar con agitación hasta llegar a 98 ºC. Cesar de calentar cuando el medio esté completamente disuelto, o bien autoclavar a 116 ºC durante sólo 1 minuto, para evitar la formación de cristales precipitados en la superficie. NO SOBRECALENTAR NI RECALENTAR, aunque en este medio MICROKIT es más difícil que aparezcan precipitados o que el agar se ablande y el asa se hunda.
PARA USO EXCLUSIVO EN LABORATORIO
MANTENGA EL BOTE BIEN CERRADO EN
LUGAR SECO, FRESCO Y OSCURO
DESHIDRATADO CODIGO: DMT142
CONTROL DE CALIDAD DEL MEDIO
Realizado en nuestro laboratorio; es prudente repetirlo en su laboratorio siempre que varíen las condiciones (más de 3 meses sin usar, tras desinfectar laboratorio, tras conservar a alta Tª, cuando adquiere aspectos extraños aunque no haya llegado la fecha de caducidad teórica de la etiqueta,…)
DESHIDRATADO: Polvo fino, Calabaza PREPARADO: Estéril, Calabaza
EVALUACIÓN DEL RENDIMIENTO ISO/TS 11133-2 (Aplicando el método ISO 6579, ISO 12824, o el indicado en el Manual MICROKIT actualizado), 24-48 h a 37 ºC:
Salmonella abony WDCM00029, Excelente, tras inocular <100 ufc, crecen >50%. Colonias transparentes con centro negro. PR > 0,5, en concreto >50-96% de colonias respecto al número de ufc certificadas e inoculadas en TSA; esta variabilidad de la productividad depende de la composición y carga de la flora acompañante inoculada. Si procede de enriquecimiento, buen crecimiento en estría de colonias transparentes con centro negro, medio amoratado.
Shigella flexneri WDCM00126, Colonias incoloras-rosadas, buen crecimiento.
- coli WDCM00013, Inhibición parcial (colonias amarillas) o total.
Enterococcus faecalis WDCM00009, Inhibición completa: Ni una sola colonia.
PRESENTACIÓN: MEDIO DESHIDRATADO, TUBOS.
NOTA
Se utiliza para aislar enterobacterias patógenas especialmente Salmonella y Shigella. El desoxicolato sódico reduce el crecimiento de coliformes. La degradación de azúcares (Xylosa, lactosa y sacarosa) en ácidos se detecta por el viraje a amarillo del rojo fenol. La formación de sulfuro de hidrógeno se detecta por la aparición de óxido de hierro negro en el centro de las colonias. Las bacterias que descarboxilan la lysina en cadaverina se reconocen por la formación de un color púrpura en la periferia de las colonias, resultado de la alcalinización.
MEJORAS DE MICROKIT
Hemos observado que en la mayoría de marcas aparecen precipitados/cristalizaciones en la placa varios días tras su preparación. Y en otras muchas marcas el agar es friable (el asa se hunde al sembrar en estría).
Todo esto no sucede en el XLD de MICROKIT:
https://www.microkit.es/fichas/XLD-AGAR.pdf
Si como segundo medio de aislamiento que la ISO 6579 te exige emplear, eliges el Cromosalm (en la ISO lo llaman ABC Agar),
te garantizamos la máxima fiabilidad en tus resultados,
ya que este medio reduce al máximo los falsos positivos típicos de otros medios cromogénicos, al tener 2 cromógenos: uno específico para Salmonella y otros para las demás Enterobacterias que dan falsos positivos en los medios Magenta-Gal:
https://www.microkit.es/fichas/ABC-CROMOSALM-MICROKIT-AGAR.pdf
SIEMBRA
En superficie, por estría, a partir del enriquecimiento. Paralelamente sembrar en placas de otros medios de cultivo selectivos. Incubar 48 horas a 37 ºC aproximadamente.
INTERPRETACIÓN
Colonias amarillas, con o sin centro negro: Escherichia, Citrobacter, Enterobacter, Proteus, Serratia, Klebsiella. Las colonias rojas, sin centro negro, son de Shigella, Providencia, Salmonella, Proteus, Pseudomonas. Colonias rojas con centro negro: Salmonella, Arizona, Edwardsiella. Las colonias incoloras con o sin centro negro son de Salmonella, Pseudomonas.
El usuario final es el único responsable de eliminar los microorganismos de acuerdo con la legislación medioambiental vigente. Autoclavar antes de desechar a la basura.
Fabricado en la UE por MICROKIT desde 1989, bajo ISO 9001, ISO 11133 y GMPs, revisado en Febrero-2021
Solicite los precios actualizados en microkit@microkit.es
Si tiene dudas técnicas contacte con consultastecnicas@microkit.es
Haga sus pedidos en pedidos@microkit.es